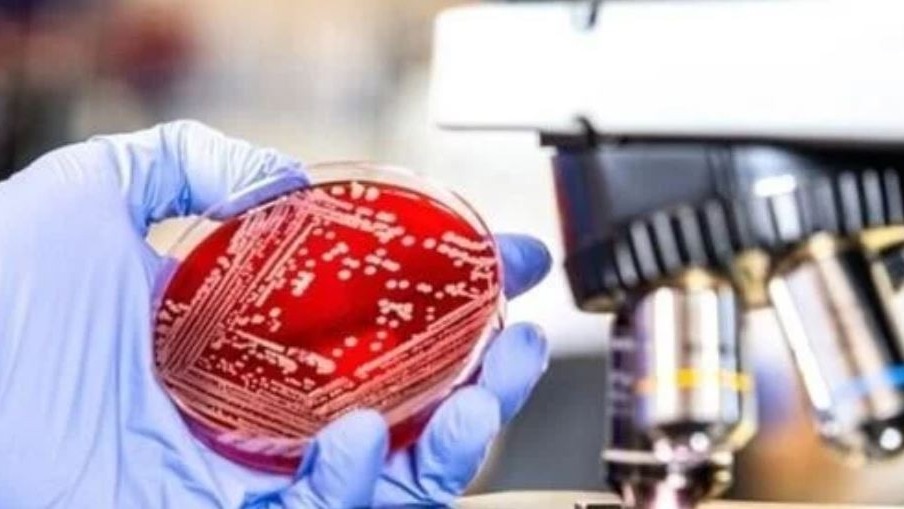
India lags in antibacterial research amid mounting global antimicrobial resistance crisis

The data emphasises disparities in innovation and resources across countries, with lower-middle-income countries, including India, contributing only 4%.
The data emphasises disparities in innovation and resources across countries, with lower-middle-income countries, including India, contributing only 4%.
The data emphasises disparities in innovation and resources across countries, with lower-middle-income countries, including India, contributing only 4%.
The data emphasises disparities in innovation and resources across countries, with lower-middle-income countries, including India, contributing only 4%.India contributes only 1% to the global antibacterial research and development (R&D) pipeline, according to data released by the World Health Organization (WHO). The WHO highlighted that 84% of antibacterial R&D is concentrated in high-income countries, with another 12% in upper-middle-income economies. The data emphasises disparities in innovation and resources across countries, with lower-middle-income countries, including India, contributing only 4%.
This translates to a limited number of new antibacterial agents being developed in these regions. China and the Russian Federation contribute 3% and 2%, respectively, slightly outpacing India and South Africa, each contributing 1%. Antimicrobial resistance (AMR), driven by the misuse and overuse of antibiotics, poses a growing public health crisis. The report identifies a need for new, innovative antibacterial agents to combat drug-resistant bacteria.
The current pipeline includes 97 antibacterial agents, up from 80 in 2021, but only 12 are considered innovative, and 4 target WHO's 'critical' priority pathogens, highlighting an innovation deficit. While the number of antibacterial agents in clinical development has risen from 80 in 2021 to 97 in 2023, the report highlights an urgent need for innovative solutions to combat drug-resistant bacteria.
First introduced in 2017, the WHO’s annual report on Antibacterial agents assesses the adequacy of current R&D against infections caused by the most threatening drug-resistant bacteria listed in the 2024 WHO bacterial priority pathogen list (BPPL). Both the report and the pathogen list aim to guide antibacterial R&D to tackle the escalating threat of AMR.
“Antimicrobial resistance is only getting worse, yet we’re not developing new trailblazing products fast enough to combat the most dangerous and deadly bacteria. Despite the authorization of new products, access remains a significant hurdle across different income brackets,” said Dr. Yukiko Nakatani, WHO’s Assistant Director-General for Antimicrobial Resistance.
The pipeline, though expanded, lacks sufficient innovation, the agency said. Of the 32 antibiotics under development for BPPL infections, only 12 are considered innovative, and a mere four are effective against at least one WHO ‘critical’ pathogen. However, there is hope with the exploration of non-traditional biological agents, such as bacteriophages and immune-modulating agents, though they face regulatory and clinical challenges.
Since July 2017, 13 new antibiotics have been authorised, but only two represent new chemical classes, highlighting the challenge of developing novel antibacterials. Additionally, three non-traditional agents, targeting the gut microbiota to prevent recurrent infections, have been approved, said the report.
The report called for greater transparency and collaboration in the pipeline, noting that this could stimulate more interest and funding for innovative antibacterial agents.